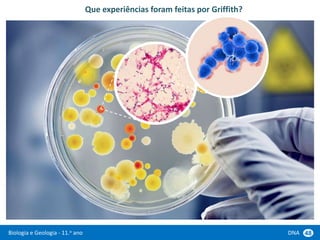
Biologia e Geologia - 11.o ano DNA 48
Que experiências foram feitas por Griffith?

Este documento descreve experiências realizadas por cientistas para descobrir a estrutura e função do DNA. Em resumo:
1) Griffith descobriu que bactérias não patogénicas podem se tornar patogénicas após exposição a bactérias patogénicas mortas.
2) Hershey e Chase marcaram radioativamente o DNA e proteínas de vírus para determinar qual entra na célula hospedeira durante a infecção, concluindo que é o DNA.
3) Watson e Crick